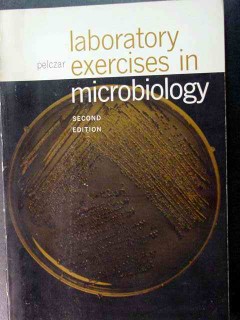
laboratory exercises in microbiology michael pelczar book laboratory exercises in microbiology michael pelczar book

Science Books
Vintage Science Books
Marvelous unique Science Books including 1001 Celestial Wonders Observed with Home Built Instruments, Alternating Current Circuits, American Journal of Archaeology, Anthropological Theory by Warms, Astrogeological Events in China by Xu Dao Yi, Birds in Our Neighborhood signed by Olson and Barker, Birds of Prey by Scholz, Clastic Tide Facies by George deVries Klein, Cooperative Plan in Geophysical Education, Electronics in the Life Sciences, Elements of Geology, ERTS1 A New Window on Our Planet signed by Ferrigno Williams, Field Collecting Gemstones and Minerals by Sinkankas, First Lessons in Zoology by Kellogg, Geochemistry of Petroleum by John Hunt, Heat by James Cork, Illustrated Petroleum Reference, Invertebrate Paleontology by Twenhofel, Laboratory Manual for Zoology, Laboratory Manual for Chemistry, Manual of Field Geology, Mission to Earth, Optical Crystallography, Penetrability Illustrated by Lawson, Rocks and Mineral by Skinner, Structural Geology, Changing World of the Ice Age, The Story of The Heavens by Sir Robert Ball, and many more! Many of these books are vintage, out of print, and some are signed. They would make a sensational gift!
introduction to physical geology william miller vintage book
Hard covered book titled AN INTRODUCTION TO PHYSICAL GEOLOGY more. WITH SPECIAL REFERENCE TO NORTH AMERICA by William J. Miller, 1935, Third Edition, Second Printing. 465 pages. Chapters include: Instability of the Earth's Crust, Materials of the Earth - Minerals, Materials of the Earth - Rocks, Rock Weathering, Structure of the Earth's Crust, The Work of Streams, Glaciers and Their Work, Geological Action of Wind, The Sea and Its Work, Volcanoes, Subsurface Water, Mountains, Plateaus and Plains, Origin and less
$21.00 $15.75
italy in space before after sirio luciano ragno bruno amatucci book
Hard covered book titled ITALY IN SPACE BEFORE AND AFTER SIRIO more. by Luciano Ragno and Bruno Amatucci, Edited by Fratelli Palombi, 1978, 285 pages, (very heavy book). This is the story of Italian space events. It is written in a journalistic style, but also complete with technical and scientific details, considering the events also at European and World levels. The words have been quoted, to the maximum possible extent, from those who lived the events. The original drawings by Alfonso Artioli and many color pictures five an extensive visual support to the st less
$19.99 $14.99
killers of the seas ed ricciuti jellyfish puffer ciguatera shark book
Soft covered book titled KILLERS OF THE SEAS by Edward R. Ricciuti, 1975, 308 pages more. ISBN: 0020636504Stories of the terrors of the deep are as ancient as man's ability to tell them. Scientists, who once dismissed these tales a legend or imagination, are now finding that there are creatures of the sea just as terrible as those in the legends. This is a scientifically accurate and compelling chilling account of the dangerous inhabitants of our oceans, rivers, lakes, and streams. Augmenting his own experience with that of oceanographers and ichthyologists from all over th less
$7.00 $5.25
laboratory exercises in microbiology michael pelczar book
Soft covered book titled LABORATORY EXERCISES IN MICROBIOLOGY by Michael Pelczar, Jr more., Second Edition. 1965, 344 pages.Topics include: THE MICROSCOPE SURVEY OF MICROORGANISMS BACTERIAL MORPHOLOGY & STAINING METHODS MEDIA PURE CULTURE TECHNIQUES BIOCHEMICAL ACTIVITIES OF BACTERIA CHARACTERIZATION OF UNKNOWNS HIGHER PRETESTS: MOLDS, YEASTS, PROTOZOA, AND ALGEA VIRUSES CONTROL OF MICROBIAL POPULATIONS: PHYSICAL AGENTS CONTROL OF MICROBIAL POPULATION: CHEMICAL AGENTS MICROORGANISMS & DISEASES APPLIED MICROBIOL less
$9.00 $6.75
laboratory manual for zoology tracy storer robert usinger vintage book
Hard covered book titled LABORATORY MANUAL FOR ZOOLOGY by Tracy Storer and Robert Usinger, 1958, cloth bound, 181 pages more. This book is divided into two parts: General Animal Biology, and The Animal Kingdom. Some of the topics include: Microscopes and their use, The frog, Amoeba, Jellyfish, Fluke, Starfish, Fresh-water Clam, Crayfish, Grasshopper, Honeybee, and much more. This vintage book is in VG condition, pages clean and intact, and the binding is tight. Light foxing present inside front & rear cover. Cover is lightly soiled. Don't less
$20.00 $15.00
laboratory manual for zoology tracy storer vintage book
Hard covered book titled LABORATORY MANUAL FOR ZOOLOGY by Tracy Storer, Professor of Zoology, Emeritus University of California, Davis, and Robert Usinger Professor of Entomology University of California, Berkeley, 3rd Edition, 1958, 181 pages more. This remarkable book was designed for the introductory course in zoology in college or university. It includes some general instructions for students, detailed exercises on the structure and physiology of the grog, others on the general principles of animal biology, and a series on common representatives of the principal groups of invertebrates. VG+ condition. Pages clean and intact, binding is tight. A wonderful addition for any zoologist's collection. less
$15.00 $11.25
laboratory manual general chemistry william hale vintage book
Hard covered book titled A LABORATORY MANUAL OF GENERAL CHEMISTRY by William J more. Hale Associate Professor of General Chemistry in the University of Michigan, New York The Macmillan Company 1919. This book presents experimental general chemistry in a complete and detailed form and puts great emphasis upon the correlation of all results. It is constructed so that all questions under each heading are consecutively numbered. These same numbers appear also upon the opposite or blank pages and indicated positions for the records. Upon the form and accuracy of these records t less
$18.00 $13.50
langes handbook of chemistry norbert adolph vintage book
Soft covered book titled HANDBOOK OF CHEMISTRY, A Reference Volume for All Requiring Ready Access to Chemical and Physical Data used in Laboratory Work and Manufacturing more. Compiled and Edited by Norbert Adolph Lange, Ph.D., 1952, Eight Edition. 1998 pages. Topics include: First Aid Measures for Accidents and Antidotes of Poisons, Modern Concepts of Matter, Periodic Arrangements of the Elements, Table of Nuclides (Isotopes), Properties of Minerals, Inorganic Chemical Nomenclature, Name and Formulas of Organic Radicals, Physical Consistence of Urine & Blood, Outline for Qualitative Analysis, Trade Names of Chemicals, Solv less
$20.00 $15.00
life at the edge scientific american james gould carol grant book
Soft covered book titled READINGS FROM SCIENTIFIC AMERICAN LIFE AT THE EDGE more. Edited by James Gould and Carol Grant Gould, 1989. This book is an exciting collection of articles that shows us how life manages to eke out an existence where, by all rights, it shouldn't and helps us to appreciate the roles of energy and the building block elements in the cycles of life. Extraordinarily well written and full of the excitement of discovery, it gives a glimpse at the blind, pragmatic, wonderfully inventive nature of natural selection. Book is in VG condition. 162 pages less
$7.00 $5.25
life in the reefs and in the deep les line george reige book
Hard covered book titled THE WORLD BOOK OF LIFE IN THE REEFS AND IN THE DEEP by Les Line and George Reiger, 1982 more. 95 pages. Filled with full page color photographs, this dazzling book will take you on a journey under the ocean, first to a coral reef during the day, next to a coral reef at night, then to the cold depths of an ocean abyss where there is no light , and finally on the open sea. This incredible book is in VG condition. Pages are clean and intact. It would make a sensational addition to your library! less
$9.99 $7.49
man and his physical universe richard wistar science book
Hard covered book titled MAN AND HIS PHYSICAL UNIVERSE by Richard Wistar, 1966, Second Edition, 376 pages more. Topics include: Weather, Photography and Wave Motion, Electricity and Magnetism, Atoms in Action, The Solar System and Beyond, The Story of the Earth. This book is in VG condition, pages clean and intact,and the binding is tight. The dust jacket is faded, scuffed and has some tears at the edges. The cover of the book is in Good condition. A must have for your science library! less
$12.99 $9.74
manual of biological forms george baitsell biology vintage book
Hard covered book titled MANUAL OF BIOLOGICAL FORMS by George Baitsell, 1925, Norwood Press, 410 pages more. Topics include: ORGANIZATION OF LIVING MATTER AMOEBA PLEUROCOCCUS EUGLENA PARAMECIUM VORTICELLA BACTERIA YEAST BREAD MOLD VOLVOX SPIROGYA MOSS FERN FLOWERING PLANTS HYDRA OBELIA EARTHWORM CRAYFISH HONEY BEE CLAM FROG VERTEBRATE DEVELOPMENT LABORATORY DIRECTIONSThis vintage book is in Good condition, pages intact, and the binding is tight. Writing present on some pages and inside front and back covers. Old tape repair/reinfo less
$12.50 $9.38
manual of field geology robert compton vintage book
Hard covered book titled MANUAL OF FIELD GEOLOGY by Robert Compton, 1962 more. 378 pages. Chapters include: Observing and Collecting Data and Samples, The Compass Traverse, Mapping Geologic Features on Aerial Photographs, Control for Geologic Maps, Detailed Mapping and Sampling, Field Work with Volcanic Rocks, Field Work with Metamorphic Rocks, and much more. This vintage book is in VG condition. Pages are clean and intact, and the binding is tight. A previous owner's name stamped inside front cover and written on the cover page. A must have less
$53.00 $39.75
manual of vertebrate animals david starr jordan vintage book
Hard covered book titled MANUAL OF THE VERTEBRATE ANIMALS of the Northeastern United States Inclusive of Marine Species by David Starr Jordan, 13th Edition, completely revised and enlarged and with illustrations, 1929, 446 pages more. Topics include: LEPTOCARDII CYCLOSTOMI ELASMOBRANCHII (SHARKS & RAYS) HOLOCEPHALI PISCES (TRUE FISHES) AMPHIBIA REPTILIA AVES (BIRDS) MAMMALIA (THE MAMMALS) This vintage book is in VG condition, pages clean and intact, and the binding is tight. A previous owner's signature inside the front cover. Foxing on the outer page edges. Don't miss the opportunity to add this sensational book to your library! less
$25.00 $18.75
marine invertebrates and plants of living reef patrick colin book
Hard covered book titled MARINE INVERTEBRATES AND PLANTS OF THE LIVING REEF by Dr more. Patrick Colin, with 432 color photographs, 1988. 512 pages. Topics include: Reefs in the Caribbean Sea, Phylum Porifera: Sponges, Phylum Arthrodpoda Crustaceans, Marine Plants, Flowing Plants, and much more. Full of beautiful color photographs, this book is in VG+ condition. Pages are clean and intact, and the binding is tight. A must have for anyone interested in marine life! less
$10.00 $7.50
microtechnique of inorganic analysis benedetti pichler vintage book
Hard covered book titled INTRODUCTION OF THE MICROTECHNIQUE OF INORGANIC ANALYSIS by A more.A. Benedetti-Pichler, 1942, 302 pages.Topics include: APPARATUS FOR GENERAL USE QUALITATIVE ANALYSIS, CONFIRMATORY TESTS, MICROTECHNIQUE OF QUALITATIVE ANALYSIS GRAVIMETRIC DETERMINATIONS TITRIMETRIC DETERMINATIONSThis vintage book is in VG+ condition, pages clean and intact, and the binding is tight. Don't miss the opportunity to add it to your library! less
$39.99 $29.99